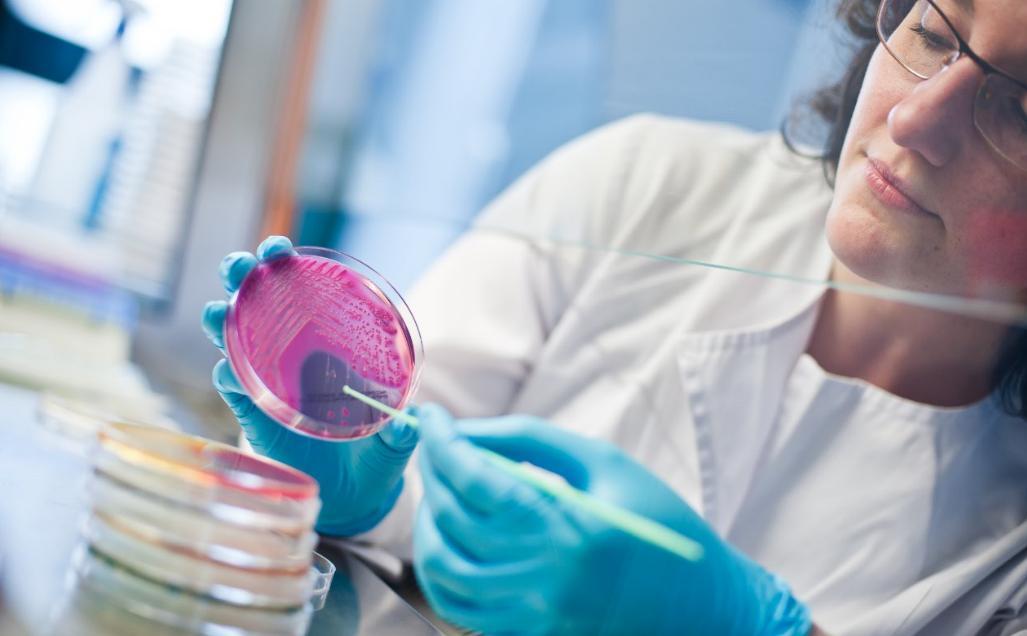

Przedstawiciele wrocławskiej spółki BIOAVLEE z ul. Krakowskiej podkreślają, że ich robot diagnostyczny Bioavlee to kompaktowe urządzenie, które może obsłużyć każda osoba po zaledwie kilkuminutowym przeszkoleniu. Pobrana próbka np. ze skóry, ucha, oka itp. umieszczana jest w bardzo prosty sposób w maszynie, która uruchomiona przyciskiem na wyświetlaczu wykonuje bez udziału człowieka procesy prowadzące do identyfikacji bakterii znajdujących się w próbce. Metoda wykorzystująca wiązkę lasera, rejestrację widm, chroniony patentem system optyczny i komputerową analizę obrazu jest znacznie szybsza i tańsza od stosowanych dotychczas. Dzięki temu może przyczynić się do zminimalizowania problemu profilaktycznego podawania antybiotyków zwierzętom.
źródło:Bioavlee
– Nasza metoda łączy tradycyjną hodowlę bakterii ze zdumiewającą prędkością dyfrakcji laserowej i sztucznej inteligencji. Wzorcowe obrazy widm przechowujemy w chmurze, a nasza baza wciąż rośnie. Dzięki temu jesteśmy w stanie już dziś zidentyfikować bakterie z dokładnością dochodzącą do 98 proc. Co istotne, dzieje się to w czasie od 9 do 16 godzin od momentu posiewu, sam moment rozpoznania bakterii – już po jej wyhodowaniu – zajmuje właściwie kilka sekund – tłumaczy dr inż. Damian Andrzejewski, CTO Bioavlee, absolwent Politechniki Wrocławskiej Wydziału Podstawowych Problemów Techniki.
Skuteczna farmakoterapia
Przedstawiciele firmy dodają, że z ich metody i urządzenia będą mogły skorzystać firmy i instytucje stosujące na co dzień badania mikrobiologiczne – np. po to, aby przeprowadzić skuteczną farmakoterapię lub by ocenić czystość mikrobiologiczną pobranego materiału. Wśród zainteresowanych rozwiązaniem mogą znaleźć się w pierwszej kolejności kliniki weterynaryjne, a z czasem także przemysł i laboratoria.
Zamiast antybiotyków
Wrocławscy naukowcy podkreślają, że badania mikrobiologiczne są dziś stosowane w weterynarii. Ze względu na ograniczony budżet, czas i ograniczony dostęp do urządzeń badawczych producenci często decydują się nie na badania, a na profilaktyczne zastosowanie bakteriobójczych antybiotyków.
– Według Światowej Organizacji Zdrowia weszliśmy już w erę postantybiotykową. Ze względu na zbyt beztroskie stosowanie antybiotyków bakterie stały się na nie odporne. Europejskie Centrum Profilaktyki i Kontroli Zakażeń podaje, że każdego roku około 25 tys. pacjentów w Unii Europejskiej umiera z powodu zakażeń wywołanych przez bakterie oporne na wszystkie dostępne antybiotyki. Z drugiej strony dane dotyczące zastosowania antybiotyków w przemyśle, weterynarii czy medycynie są zatrważające. W Stanach Zjednoczonych około 80 proc. wszystkich antybiotyków podaje się zdrowym zwierzętom, bywa, że profilaktycznie antybiotyki stosuje się nawet przy uprawie jabłek. A to wszystko po to, aby walczyć z bakteriami, które mogą zagrozić uprawom, hodowlom czy też zdrowiu ludzi i zwierząt. Profilaktyczne zastosowanie antybiotyków można by zminimalizować, upowszechniając tanią i szybką metodę identyfikacji bakterii. Taki pomysł stał się zaczątkiem technologii opracowanej przez Bioavlee – mówi dr inż. Damian Andrzejewski.
Trwają testy urządzenia
Obecnie zespół Bioavlee, w skład którego wchodzą m.in. absolwenci Politechniki Wrocławskiej i Uniwersytetu Wrocławskiego, kończy prace nad urządzeniem. Będzie ono udostępniane klientom na zasadzie abonamentu.
– Nasze rozwiązanie jest proste w obsłudze i nie wymaga zaangażowania wykwalifikowanego personelu. Wystarczy przygotować próbkę, która następnie trafia do maszyny. Po kilk, kilkunastu godzinach wyniki badania są przesyłane do klienta. Ze względu na to, że zdecydowaliśmy się udostępniać nasze urządzenie na zasadzie opłat abonamentowych, niedrogie badania mikrobiologiczne będą dostępne nawet dla małych gabinetów – mówi Marcin Bruś, odpowiedzialny za marketing i strategię w Bioavlee.
Przedstawiciele firmy dodają, że obecnie trwają testy urządzenia w zakładach produkcyjnych w Szwajcarii i Polsce. Urządzenia ma być dostępne na rynku w 2017 r.
jr/Bioavlee